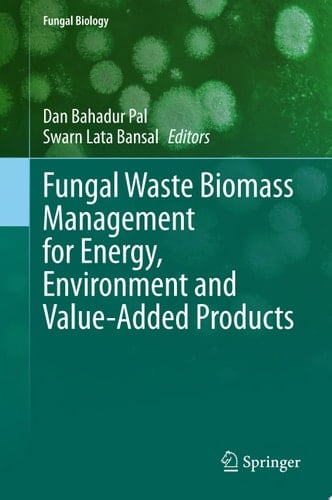
Fungal Waste Biomass Management for Energy, Environment and Value-Added Products

Bioconversion of waste is a natural process aiding in the recovery of resources and biotechnology-facilitated natural recycling processes. Biotechnological treatments to food processing wastes found in large quantities can produce useful end products, such as microbial biomass protein, while wastes are also purified during the process. Fungi as microorganism and as fungal biomass have been used for many applications such as enzyme production for biomedical, biorefinery, and other industries. Additionally, environmental pollution is a crucial problem for the entire world, and it is growing continuously. Continuous growth of pollution is resulting harmful changes like global warming and pollution of air, water, and soil. These changes are directly associated with various activities like uncontrolled agricultural practices, deforestation, urbanization, accumulation of huge amounts of agricultural and food waste, improper dumping of naturally occurred waste and forest residues, etc. Therefore, proper utilization of these wastes may be a better solution for this problem. Fungal-based biomass materials are good sources of carbohydrates, oil & fats, cellulosic content, and other useful chemical components which can be converted into value-added products for production of clean energy, bioenergy, bio-adsorbents, and useful chemicals. This book provides information, processes, and ideas for the conversion of waste into useful and consumable enzymes through biological approaches. Within the last few years, researchers have found that food and agricultural waste biomass have the potential to produce value-added products. Technological information for the production of nutraceuticals and organic acids from the agro-waste are also covered in this book.
Page Count:
325
Publication Date:
2025-03-10
ISBN-10:
3031825993
ISBN-13:
9783031825996
No comments yet. Be the first to share your thoughts!